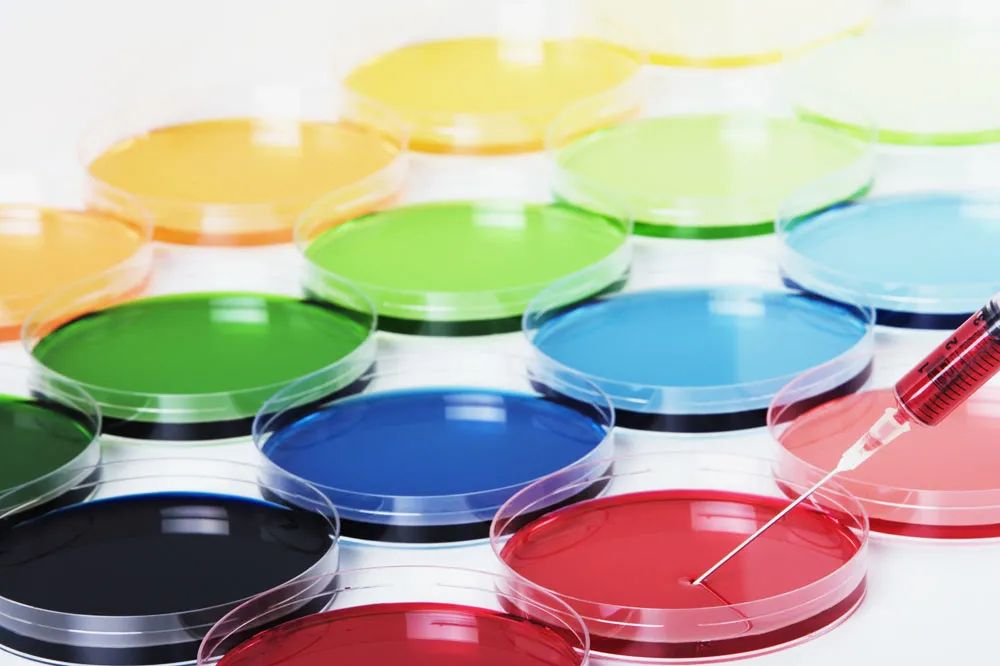
轻微水肿的症状和治疗,水肿反反复复严重吗

51岁的王女士(化名)被反反复复的颜面、手足等部位水肿困扰了30余年,大约每月都会发作1次。她曾因喉部水肿引起的呼吸困难、窒息就诊于当地多家医院的急诊科、耳鼻喉科,给予吸氧、抗组胺药、激素注射等治疗,水肿未见明显缓解,甚至已经做好了气管切开的准备。她也曾因腹部疼痛、腹腔积液就诊于消化科、急诊科、胃肠外科及普通外科,医生曾诊断为“急腹症”“胰腺炎急性发作”“阑尾炎”等,甚至已经到了准备手术的地步。
更加不幸的是,在她的家族中4代人里有10人也曾出现过不同部位的水肿,其中一位亲属还因为水肿发生在了喉部而窒息去世。尽管如此,她仍然不知道自己是患了什么疾病。
几年前,她来到我院皮肤性病科就诊,终于解开了这个疾病的谜团。
原来,王女士患的是一种名为“遗传性血管性水肿(HAE)”的罕见疾病。

HAE是一种常染色体显性遗传疾病,全球患病率约为1:50000,其主要特征是 反复发生皮肤和黏膜水肿,水肿可累及颜面、四肢、躯干,生殖器和胃肠道等,而当水肿累及呼吸道时,甚至有窒息死亡风险 。

目前对此疾病的了解,绝大多数患者的病因是由于 体内的C1酯酶抑制物浓度或功能下降 导致 缓激肽水平升高 而发生水肿;另有非常罕见的病例是由于 其他基因突变导致的C1酯酶抑制物浓度和功能正常的HAE 。
鉴于其为缓激肽介导的水肿,所以常规的抗组胺药、肾上腺素和激素都对这种水肿无效,为治疗带来困难。而其发病罕见,更使得很多医生也不了解该病。据北京协和医院研究统计,中国患者从首次发病到疾病确诊平均约经历13年。
缺乏有效的检测手段是HAE经常误诊和漏诊的原因之一。2019年,我院皮肤性病科针对这一罕见病发表过《遗传性血管性水肿1家系C1抑制物基因突变分析》的论文,通过基因检测帮助HAE患者得到确诊。
随着对罕见病的日渐关注,为帮助更多的HAE患者得到确诊,我院皮肤性病科现开展相关的公益活动,即 免费检测C1酯酶抑制物浓度和功能(门诊就诊咨询),帮助疑似患者明确诊断 。
虽然疾病罕见,但我国政府和医疗卫生部门都非常关注这一少数群体。2018年,国家卫生健康委员会等5部门联合制定了《第一批罕见病目录》共涉及121种疾病,HAE就是其中之一。
2021年,用于治疗HAE急性发作的药物—— 醋酸艾替班特注射液 在中国获批。为患者减轻负担,国家医保局也于当年将这一临床急需药物纳入国家医保目录。目前,醋酸艾替班特注射液已列入辽宁省高值药品及新增谈判药品供应保障目录中,方便HAE患者在水肿发作时获得及时的药物治疗。

同时,我院皮肤性病科也积极开展学习活动,并积极联合其他相关科室进行疾病科普,让更多的医务人员能够识别这种罕见病,更好地帮助患者获得及时的诊断和治疗。
疾病罕见,
爱不罕见。
医大一院,
勇往直前。